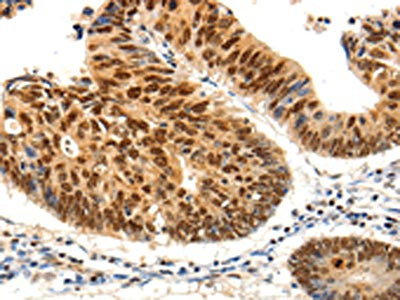

PDCD6 Antibody
-
中文名稱:PDCD6兔多克隆抗體
-
貨號:CSB-PA592469
-
規格:¥1100
-
圖片:
-
The image on the left is immunohistochemistry of paraffin-embedded Human ovarian cancer tissue using CSB-PA592469(PDCD6 Antibody) at dilution 1/25, on the right is treated with fusion protein. (Original magnification: ×200)
-
The image on the left is immunohistochemistry of paraffin-embedded Human colon cancer tissue using CSB-PA592469(PDCD6 Antibody) at dilution 1/25, on the right is treated with fusion protein. (Original magnification: ×200)
-
Gel: 10+12%SDS-PAGE, Lysate: 50 μg, Lane 1-2: Jurkat cells, hela cells, Primary antibody: CSB-PA592469(PDCD6 Antibody) at dilution 1/200, Secondary antibody: Goat anti rabbit IgG at 1/8000 dilution, Exposure time: 1 minute
-
-
其他:
產品詳情
-
Uniprot No.:
-
基因名:PDCD6
-
別名:AIP1 antibody; ALG 2 antibody; ALG-2-interacting protein 1 antibody; ALG2 antibody; ALIX antibody; Apoptosis linked gene 2 antibody; Apoptosis linked gene 2 protein antibody; Apoptosis-linked gene 2 protein antibody; FLJ42309 antibody; FLJ46208 antibody; Hp95 antibody; KIAA1375 antibody; MA 3 antibody; MA3 antibody; MGC111017 antibody; MGC119050 antibody; MGC9123 antibody; PDCD 6 antibody; Pdcd6 antibody; PDCD6_HUMAN antibody; PEF 1B antibody; PEF1B antibody; Probable calcium binding protein ALG 2 antibody; Probable calcium binding protein ALG2 antibody; Probable calcium-binding protein ALG-2 antibody; Programmed cell death 6 antibody; Programmed cell death 6-interacting protein antibody; Programmed cell death protein 6 antibody; PS 2 antibody; PS2 antibody
-
宿主:Rabbit
-
反應種屬:Human,Mouse
-
免疫原:Fusion protein of Human PDCD6
-
免疫原種屬:Homo sapiens (Human)
-
標記方式:Non-conjugated
-
抗體亞型:IgG
-
純化方式:Antigen affinity purification
-
濃度:It differs from different batches. Please contact us to confirm it.
-
保存緩沖液:-20°C, pH7.4 PBS, 0.05% NaN3, 40% Glycerol
-
產品提供形式:Liquid
-
應用范圍:ELISA,WB,IHC
-
推薦稀釋比:
Application Recommended Dilution ELISA 1:1000-1:5000 WB 1:200-1:1000 IHC 1:25-1:100 -
Protocols:
-
儲存條件:Upon receipt, store at -20°C or -80°C. Avoid repeated freeze.
-
貨期:Basically, we can dispatch the products out in 1-3 working days after receiving your orders. Delivery time maybe differs from different purchasing way or location, please kindly consult your local distributors for specific delivery time.
-
用途:For Research Use Only. Not for use in diagnostic or therapeutic procedures.
相關產品
靶點詳情
-
功能:Calcium sensor that plays a key role in processes such as endoplasmic reticulum (ER)-Golgi vesicular transport, endosomal biogenesis or membrane repair. Acts as an adapter that bridges unrelated proteins or stabilizes weak protein-protein complexes in response to calcium: calcium-binding triggers exposure of apolar surface, promoting interaction with different sets of proteins thanks to 3 different hydrophobic pockets, leading to translocation to membranes. Involved in ER-Golgi transport by promoting the association between PDCD6IP and TSG101, thereby bridging together the ESCRT-III and ESCRT-I complexes. Together with PEF1, acts as calcium-dependent adapter for the BCR(KLHL12) complex, a complex involved in ER-Golgi transport by regulating the size of COPII coats. In response to cytosolic calcium increase, the heterodimer formed with PEF1 interacts with, and bridges together the BCR(KLHL12) complex and SEC31 (SEC31A or SEC31B), promoting monoubiquitination of SEC31 and subsequent collagen export, which is required for neural crest specification. Involved in the regulation of the distribution and function of MCOLN1 in the endosomal pathway. Promotes localization and polymerization of TFG at endoplasmic reticulum exit site. Required for T-cell receptor-, Fas-, and glucocorticoid-induced apoptosis. May mediate Ca(2+)-regulated signals along the death pathway: interaction with DAPK1 can accelerate apoptotic cell death by increasing caspase-3 activity. Its role in apoptosis may however be indirect, as suggested by knockout experiments. May inhibit KDR/VEGFR2-dependent angiogenesis; the function involves inhibition of VEGF-induced phosphorylation of the Akt signaling pathway. In case of infection by HIV-1 virus, indirectly inhibits HIV-1 production by affecting viral Gag expression and distribution.; Has a lower Ca(2+) affinity than isoform 1.
-
基因功能參考文獻:
- Up-regulation of miR-20a by HPV16 E6 exerted growth-promoting effects by targeting PDCD6 in cervical carcinoma cells. PMID: 29710555
- the t(5;21)(p15;q22) translocation could be identified only when what had seemed like a del(21)(qq) in G-banded preparations was examined using FISH and RNA-sequencing directed at finding out what lay behind the 21q-. PMID: 29672642
- ALG-2 binding to Scotin is strictly calcium dependent, indicating a role of this interaction in calcium signaling pathways PMID: 17889823
- found that targeting Requiem and Alg-2 did not result in extended culture viability, but resulted in an increase in maximum viable cell numbers and cumulative IVCD under fed-batch conditions PMID: 20571937
- the alg2 binding site is one of the key determinants of the retention kinetics of Sec31A at endoplasmic reticulum exit sites PMID: 20834162
- This is the first report showing interaction of ALG-2 with a P-body component (PATL1).PATL1 as well as DCP1A, a well-known P-body marker, co-localized with a subset of ALG-2. PMID: 22437941
- ALG-2 attenuates COPII budding in vitro and stabilizes the Sec23/Sec31A complex. PMID: 24069399
- Results show the crystal structure of the complex between ALG-2 and a peptide of Sec31A and found that the peptide binds to the third hydrophobic pocket (Pocket 3) and that ALG-2 recognizing 2 types of motifs at different hydrophobic surfaces of Sec31A. PMID: 25667979
- These results indicate that ALG-2 has an anti-apoptotic function in HeLa cells by facilitating the passage through checkpoints in the G2/M cell cycle phase. PMID: 19013425
- analysed the expression of ALG-2 in 7371 tumor tissue samples of various origin; most notably, ALG-2 was upregulated in mesenchymal tumors. PMID: 19383317
- ALG-2/Sec31A interactions were not required for the localization of Sec31A to ER exit sites per se but appeared to acutely regulate the stability and trafficking of the cargo receptor p24 and the distribution of the vesicle tether protein p115 PMID: 25006245
- Our study demonstrates that ALG-2 plays a role in the regulation of cytoskeletal rearrangement that drives cell polarization and migration in breast cancer cells. PMID: 27926525
- MAP1B heavy chain has a unique binding site for a calcium-binding protein ALG-2. PMID: 29432744
- These results suggest that a change in the intracellular calcium level plays a role in regulation of the secretory pathway via interaction of ALG-2 with MISSL and MAP1B. PMID: 28864773
- The gene copy numbers and mRNA levels for both ALG-2 and HEBP2 are significantly upregulated in breast and lung cancer. Coexpression of ALG-2 and HEBP2 markedly increases the cytoplasmic pool of ALG-2 and alters the subcellular distribution of HEBP2. Abnormalities in the ALG-2/HEBP2 interaction impairs spindle orientation and positioning during mitosis. PMID: 28004381
- The results suggest that ALG-2 acts as a Ca2+-sensitive adaptor to concentrate and polymerize TFG at endoplasmic reticulum exit sites, supporting a potential role for ALG-2 in COPII-dependent trafficking from the endoplasmic reticulum. PMID: 27813252
- ALG2 has a tumor suppressive role in glioblastoma and might be a potential target for the treatment of glioblastoma. PMID: 28300556
- miR-183 may function as an oncogene and may enhance cell proliferation by targeting PDCD6, implying a potential therapeutic target for this malignancy. PMID: 27738758
- Achieved results show that polymorphism rs3756712 is signifi cantly associated with the risk of endometriosis development in Slovak women. Polymorphism rs4957014 did not show any connection with development of endometriosis PMID: 27546697
- Our results suggest that PDCD6 may play an important role in the pathogenesis of cervical squamous cell carcinoma PMID: 25362542
- PDCD6 may represent a biomarker candidate gene that could help to identify a group of patients at high risk for recurrence and death. PMID: 24792888
- Palmitoylation sites and the N-terminal Pro-rich region were necessary for efficient secretion, but ABSs (ALG-2-binding sites) were dispensable. PMID: 23350699
- The present study provided evidence that rs4957014 and rs3756712 are associated with Uterine leiomyoma (UL) risk, the results indicated that genetic polymorphisms in PDCD6 may contribute to the development of UL. PMID: 23551056
- CHERP and ALG-2 participate in regulation of alternative splicing of IP3R1 pre-mRNA and provide new insights into post-transcriptional regulation of splicing variants in Ca(2+) signaling pathways. PMID: 24078636
- the binding of ALG-2 to IST1 is Ca(2+)-dependent PMID: 23649269
- the current study indicates that PDCD6 gene may be a new susceptibility gene to endometriosis. PMID: 23137875
- The results of this study show that rs4957014G/T is associated with an increased risk of non-small cell lung cancer (NSCLC), which suggest that PDCD6 gene single nucleotide polymorphism is a risk factor for susceptibility of NSCLC. PMID: 23167403
- we conclude that a novel p53-responsive gene PDCD6 is accumulated in the nucleus and induces apoptosis in response to DNA damage. PMID: 22712728
- PDCD6 seems to play an important role in ovarian cancer progression. PMID: 22369209
- PDCD6 exerts its anti-tumor potency by activating the p53-p21 protein for G1 phase of cell cycle progression and apoptosis PMID: 22142513
- PDCD6 may have a role in advanced gastric cancer PMID: 22161137
- programmed cell death 6 protein plays a significant role in modulating cellular angiogenesis PMID: 21893193
- ALG-2 is stabilized by dimerization through its fifth EF-hand region PMID: 11883899
- Pro/Gly/Tyr/Ala-rich hydrophobic region in Anexin XI masked the Ca(2+)-dependently exposed hydrophobic surface of ALG-2. PMID: 11883939
- The penta-EF-hand domain of ALG-2 interacts with amino-terminal domains of both annexin VII and annexin XI in a Ca2+-dependent manner. PMID: 12445460
- ALG-2 has roles in both cell proliferation and cell death. PMID: 12445461
- Data show that ALG-2 is overexpressed in liver and lung neoplasms, and is mainly found in epithelial cells in the lung. PMID: 12819013
- The down-regulation of ALG-2 in human uveal melanoma cells compared to their progenitor cells, normal melanocytes, may provide melanoma cells with a selective advantage by interfering with Ca+-mediated apoptotic signals, thereby enhancing cell survival. PMID: 15366927
- Raf-1 may mediate its anti-apoptotic function by interrupting ASK1-dependent phosphorylation of ALG-2. PMID: 15925322
- ALG-2 is recruited to endoplasmic reticulum exit sites via Ca(2+)-dependent interaction with Sec31A and in turn stabilizes the localization of Sec31A at these sites. PMID: 16957052
- ALG-2 alone evenly distributed within the cell, whereas in the presence of RBM22 the two proteins co-localized within the nucleus. PMID: 17045351
- These findings establish Sec31A as a novel target for ALG-2 and provide a framework for studies on the roles of ALG-2 in ER-Golgi transport. PMID: 17196169
- Identification of Alix-type and Non-Alix-type ALG-2-binding sites in human phospholipid scramblase 3: differential binding to an alternatively spliced isoform and amino acid-substituted mutants PMID: 18256029
- lower mRNA expression levels of PDCD6 were correlated significantly with a poor overall survival in gastric cancer. PMID: 18957060
- Results describe the crystallization and structural analysis of N-terminally truncated human ALG-2. PMID: 18997320
- ALG-2 acts as a Ca(2+) sensor that modulates the function of MCOLN1 along the late endosomal-lysosomal pathway. PMID: 19864416
- Apoptosis-linked gene 2 binds to the death domain of Fas and dissociates from Fas during Fas-mediated apoptosis in Jurkat cells. PMID: 11606059
顯示更多
收起更多
-
亞細胞定位:Endoplasmic reticulum membrane; Peripheral membrane protein. Cytoplasmic vesicle, COPII-coated vesicle membrane. Cytoplasm. Nucleus. Endosome.
-
數據庫鏈接:
Most popular with customers
-
-
YWHAB Recombinant Monoclonal Antibody
Applications: ELISA, WB, IHC, IF, FC
Species Reactivity: Human, Mouse, Rat
-
Phospho-YAP1 (S127) Recombinant Monoclonal Antibody
Applications: ELISA, WB, IHC
Species Reactivity: Human
-
-
-
-
-